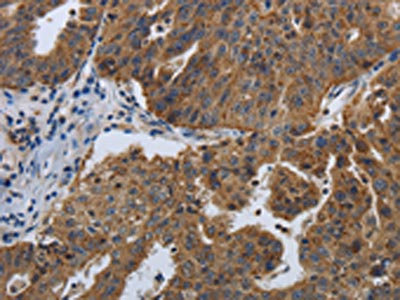

SPAG4 Antibody
-
中文名稱(chēng):SPAG4兔多克隆抗體
-
貨號(hào):CSB-PA989865
-
規(guī)格:¥1100
-
圖片:
-
The image on the left is immunohistochemistry of paraffin-embedded Human ovarian cancer tissue using CSB-PA989865(SPAG4 Antibody) at dilution 1/50, on the right is treated with synthetic peptide. (Original magnification: ×200)
-
The image on the left is immunohistochemistry of paraffin-embedded Human lung cancer tissue using CSB-PA989865(SPAG4 Antibody) at dilution 1/50, on the right is treated with synthetic peptide. (Original magnification: ×200)
-
Gel: 12%SDS-PAGE, Lysate: 40 μg, Lane 1-2: Hela cells, K562 cells, Primary antibody: CSB-PA989865(SPAG4 Antibody) at dilution 1/1100, Secondary antibody: Goat anti rabbit IgG at 1/8000 dilution, Exposure time: 30 seconds
-
-
其他:
產(chǎn)品詳情
-
Uniprot No.:
-
基因名:SPAG4
-
別名:SPAG4; SUN4; Sperm-associated antigen 4 protein; Outer dense fiber-associated protein SPAG4; SUN domain-containing protein 4
-
宿主:Rabbit
-
反應(yīng)種屬:Human
-
免疫原:Synthetic peptide of Human SPAG4
-
免疫原種屬:Homo sapiens (Human)
-
標(biāo)記方式:Non-conjugated
-
抗體亞型:IgG
-
純化方式:Antigen affinity purification
-
濃度:It differs from different batches. Please contact us to confirm it.
-
保存緩沖液:-20°C, pH7.4 PBS, 0.05% NaN3, 40% Glycerol
-
產(chǎn)品提供形式:Liquid
-
應(yīng)用范圍:ELISA,WB,IHC
-
推薦稀釋比:
Application Recommended Dilution ELISA 1:2000-1:10000 WB 1:500-1:2000 IHC 1:50-1:200 -
Protocols:
-
儲(chǔ)存條件:Upon receipt, store at -20°C or -80°C. Avoid repeated freeze.
-
貨期:Basically, we can dispatch the products out in 1-3 working days after receiving your orders. Delivery time maybe differs from different purchasing way or location, please kindly consult your local distributors for specific delivery time.
-
用途:For Research Use Only. Not for use in diagnostic or therapeutic procedures.
引用文獻(xiàn)
- Integrated multi-level omics profiling of disulfidptosis identifis SPAG4 as an innovative immunotherapeutic target in glioblastoma S Chen, M Zeng, T Chen, H Ding, JH Lin, F Ye,Frontiers in Immunology,2024
相關(guān)產(chǎn)品
靶點(diǎn)詳情
-
功能:Involved in spermatogenesis. Required for sperm head formation but not required to establish and maintain general polarity of the sperm head. Required for anchoring and organization of the manchette. Required for targeting of SUN3 and probably SYNE1 through a probable SUN1:SYNE3 LINC complex to the nuclear envelope and involved in accurate posterior sperm head localization of the complex. May anchor SUN3 the nuclear envelope. Involved in maintenance of the nuclear envelope integrity. May assist the organization and assembly of outer dense fibers (ODFs), a specific structure of the sperm tail.
-
基因功能參考文獻(xiàn):
- SPAG4, in cooperation with Nesprin3, has a fundamental pathological function in the migration of lung carcinoma cells. PMID: 29901114
- SPAG4 knockdown reduces the invasion capability of RCC cells. PMID: 23818324
- SPAG4 is an independent prognostic factor in renal cell carcinoma and plays a crucial role in cytokinesis to defend against hypoxia-induced tetraploid formation. PMID: 23602831
-
亞細(xì)胞定位:Membrane; Multi-pass membrane protein. Cytoplasm, cytoskeleton. Cytoplasm, cytoskeleton, flagellum axoneme. Nucleus envelope. Nucleus inner membrane.
-
組織特異性:Predominantly epressed in testis. Expressed in ejaculated spermatozoa (at protein level).
-
數(shù)據(jù)庫(kù)鏈接:
Most popular with customers
-
-
YWHAB Recombinant Monoclonal Antibody
Applications: ELISA, WB, IHC, IF, FC
Species Reactivity: Human, Mouse, Rat
-
Phospho-YAP1 (S127) Recombinant Monoclonal Antibody
Applications: ELISA, WB, IHC
Species Reactivity: Human
-
-
-
-
-